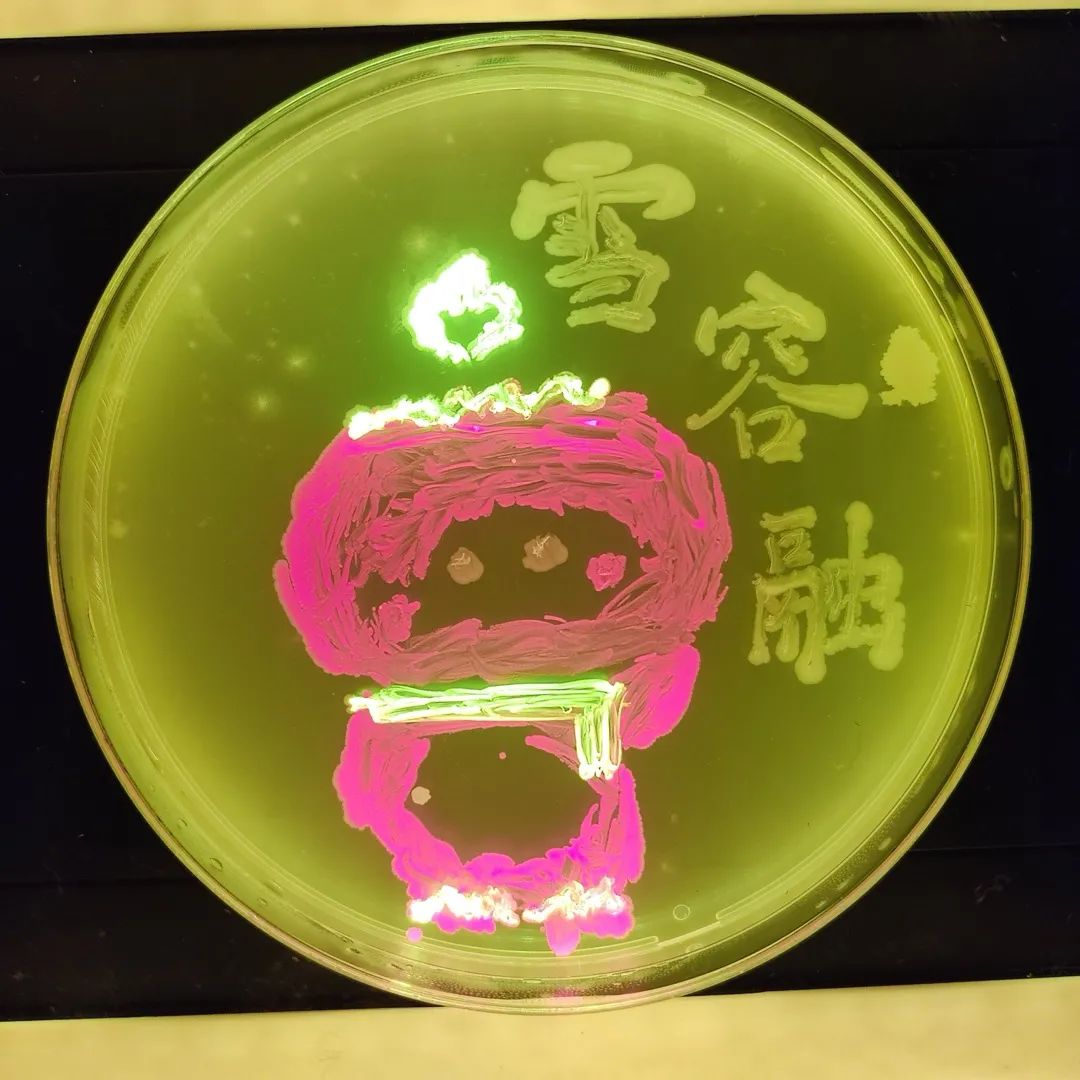
东富龙获得实用新型专利授权:“一种洁净室内培养皿微生物检测辅助装置”
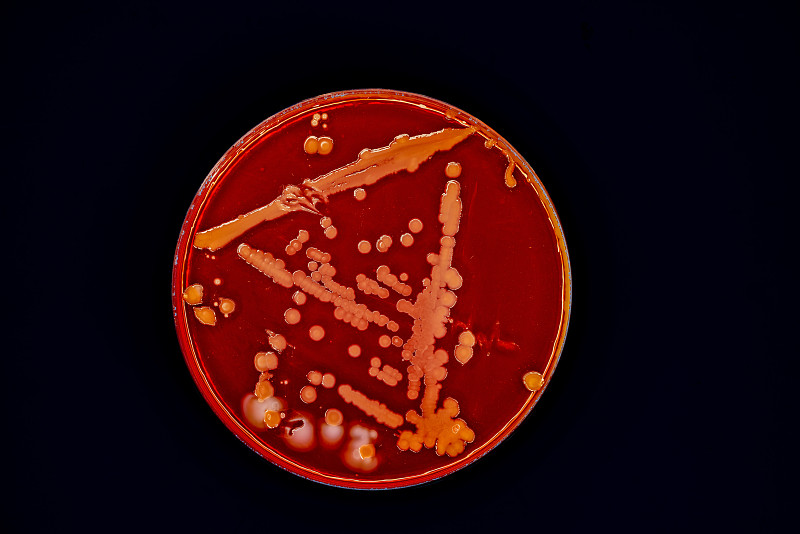
东富龙获得实用新型专利授权:“一种洁净室内培养皿微生物检测辅助装置”

东富龙获得实用新型专利授权:“一种洁净室内培养皿微生物检测辅助装置”
证券之星消息,根据天眼查APP数据显示东富龙(300171)新获得一项实用新型专利授权,专利名为“一种洁净室内培养皿微生物检测辅助装置”,专利申请号为CN202520582819.7,授权日为2026年3月27日。
图片来源于网络,如有侵权,请联系删除
专利摘要:本实用新型揭示了一种洁净室内培养皿微生物检测辅助装置,包括:存放架,在竖直方向具有多个层叠且独立设置的摆放托盘,摆放托盘用于承载培养皿本体;操作台,设置在存放架的一侧;转移机构,能够沿竖直方向移动,且绕其轴心方向旋转,用于将培养皿本体由摆放托盘夹持并输送至操作台上或由操作台夹持并输出至摆放托盘内,并对培养皿本体的盒体进行限位;翻盖机构,设置在操作台远离存放架的一侧。本实用新型通过上述设置,实现培养皿本体从存储、定位、开盖、检测以及关盖全流程自动化控制的功能,以此消除人为操作所带来的污染风险,相应的,亦可满足对不同高度摆放托盘内培养皿本体的连续检测需求,达到提升检测速率的目的。
图片来源于网络,如有侵权,请联系删除
今年以来东富龙新获得专利授权31个,较去年同期增加了19.23%。结合公司2025年中报财务数据,2025上半年公司在研发方面投入了1.58亿元,同比增2.95%。
通过天眼查大数据分析,东富龙科技集团股份有限公司共对外投资了28家企业,参与招投标项目765次;财产线索方面有商标信息69条,专利信息1702条,著作权信息72条;此外企业还拥有行政许可143个。
数据来源:天眼查APP
以上内容为证券之星据公开信息整理,由AI算法生成(网信算备310104345710301240019号),不构成投资建议。
目录 返回
首页
